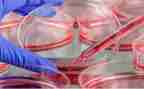

我们时常会在生活中收到很多感悟,这时候就需要学会心得体会的记录,写一篇心得体会,这样能够培养人思考的习惯,白领范文网小编今天就为您带来了机组长培训心得模板8篇,相信一定会对你有所帮助。

机组长培训心得篇1
在我矿班组长培训班这三天学习中,我受益匪浅,通过学习更加深入了解了我矿各个部门的具体工作,还有我矿现在和未来的发展情况,使我更了解兰尖,对兰尖更有感情了。我将继续学习新知识、新思维方式来改进以往的工作模式和工作方法,今后更好地为我们兰尖的发展贡献绵薄之力,为攀钢的发展添砖加瓦。
在学习中,我明白的道理就是:班组长作为兵头将尾,起着承上启下的作用,是企业有机组成部分的重要元素。只有将班组长的工作做透做细,使每一个班组成员充满生机和活力,企业才会有旺盛的生命力,才能迅速发展。特别是当前公司遇到的一系列困难,还有我矿将由露天采矿逐渐转入地下开采等一系列的变化,使得班组建设和管理就显得尤为重要。参加矿开展的这次班组长培训,对我启发很大,主要有以下体会:
第一,思想意识和素质提高了。通过这次培训,我感到作为班长必须具备较高的思想意识和素质,才能心怀全局,带动班组成员为了一个共同的目标而努力。要想干好每一项工作,一个人的思想意识和素质决定一切,好的意识和素质能把一切工作干得井井有条、合理恰当。作为班长,不但要合理安排和协调好每项工作,优化劳动组织,取得最佳工作效果,还要搞好班组的综合管理。这就需要自己平时更加注意和学习别人的工作方法,不断丰富和提高自己的意识和素质,才能保持好整个集体的和睦,团队才会有向心力、凝聚力,才能真正实现根本意义上的自主管理。
第二,安全、质量意识提高了。一直认为安全、质量只要不出事,就行了。通过这次学习认识上有了很大改变。自我感觉这不单是做表率的作用,而是认为安全不仅仅是个人行为,它是团队组织、社会的效益,是一切社会活动的基础,是社会保持稳定的前提和保障;质量方面也是如此,无论从事任何一项工作,都能坚持质量第一,而且需要做到能从换位思考的角度去面对工作中的质量问题。
第三,学习力提高了。通过培训自己的观念发生了转变,随着培训的不断深入,我越来越觉得自己的文化、业务知识太贫乏了,要不断丰富了自己的业务能力,确定学习目标,做好计划实施,不断提高自身的能力和水平。
感谢矿开展的这个培训班,给了我这次学习的机会,使我在班组管理方面有了更加深入的认识,它让我在观念上有了长足的提高,使我在前进的道路上又多了一份信心和决心,在以后的工作中会更得心应手,更有力的承担起交给我的工作任务。
机组长培训心得篇2
对于这次的培训课程,我想我只能用受益匪浅这四个字来形容了。我的脑海里留下了深刻的印象,我只恨自我才疏学浅、文笔糟糕,不能够将所有的感触都透过文字显然于纸上。但是我还是尽力绞尽脑汁,以祈求能将培训完后心中所想所获能表达出来。进一步提升我们的管理理念和解决问题的潜力,更好的履行岗位职责,适应事业部的生产经营和发展需要。透过这次培训学习使我更加的了解做一名工段长的职责、使命
此次精彩的培训学习主要心得有以下几个方面:
一、赵书记对事业部面临的形势及发展前景和事业部近期目标的讲话,在某种好处上讲,也就是对我们班组长提出了要求,怎样样完成这一目标,使生产型企业向真正好处上的事业部转变。在现场定置管理和班组管理台账讲解中,针对各个班组的实际状况,详细的讲到现场各类物品定置摆放的一些误区,以及班组台账书写中的一些错误和弊端,使我对这方面有着更清晰的认识。
二、在各位优秀班组长的管理经验介绍和交流中,更使我了解作为一名工段长我的职责是
1、协助车间主任做好车间的各项工作,参与制定修订车间有关安全生产管理制度、安全技术规程和应急预案,并负责检查员工的落实执行状况。
2、做好日常安全检查,及时整改安全隐患,及时纠正和制止违章操作,确保生产安全有序进行。
3、负责新员工及所有员工的车间级安全教育、培训和考核工作
4、负责车间动火工作,执行并检查车间动火项目安全措施的落实状况,确保动火安全。
5、做好车间内消防器材、消防设施的保养维护等日常管理工作。
6、负责车间劳动防护用品的领用、发放和监督使用工作,检查班组安全作业执行状况。
7、制定车间物料及现场卫生管理规定,负责员工的现场考核工作,督促员工做好现场卫生及设备保洁工作。
8、建立员工个人月记考核台帐,协助车间作好员工月记考核工作。负责员工生产考核统计汇总工作,协助车间做好员工生产考核工作。负责员工考勤的管理工作。
9、参加每一天班会,对安全、卫生、物料等方面进行总结,提出改善推荐。
10、协助车间做好设备基础管理工作。
三、学习了不少礼仪与修养,这次培训氟化公司一名班组长日我了解了就应如何发挥自我的情商,处理好与他人的关系。如何让自我以后的一言一行更加具有素质与修养。让自我在为人处事方面慢慢走向成熟与稳重。
学习是可贵的,培训是精彩的。透过这次可贵而精彩的培训学习,我们更进了一步。感叹与憧憬之余,我想我们只有靠自我的聪明与才智、努力与勤奋去建设好事业部,为我们的事业部更好的发展贡献自我微薄的力量。
机组长培训心得篇3
各县(区、市)煤炭工业局:
根据《关于进一步推进全国煤炭行业区队班组建设工作的意见》(中煤协会综合〔20xx〕27号)文件精神,为进一步提升全市煤矿班组队伍综合素质,加强煤矿班组建设,推动煤炭企业供给侧结构性改革和转型升级发展。经研究,决定与中国煤炭工业协会合作举办20xx年晋中市第一期“乌金蓝领工程”班组长素质强化培训班。现将有关事项通知如下:
一、培训对象
全市煤矿企业从事采煤、掘进、开拓、机电、运输、通风、地测、防治水等作业的班组长;区队长、工长;负责班组管理和班组长培训的有关部门领导(包括班组建设管理人员)及安全生产管理人员等。
二、培训形式:
脱产集中培训。
三、培训内容
1、安全知识模块:新《安全生产法》、新《煤矿安全规程》等煤矿安全生产政策法规、现场安全管理的新技术及新模式、安全风险预控、安全文化建设、现场应急处置等。
2、组织管理模块:角色转变、班组长的职责和作用、沟通艺术、执行力打造、精益生产、经济核算、班组长工作方法与领导能力艺术等。
3、专业技能模块:采、掘、开、机、运、通班组长应掌握的岗位专业岗位技能。
4、人文素质模块:国学与感恩文化、心理素质与文化修养、文明礼仪等。
5、先进经验模块:解析以国投塔山煤矿“人人都是班组长”班组建设模式、中国平煤神马集团“白国周班组管理法”。
6、事故案例分析:分析近年来发生的煤矿事故案例,剖析事故原因,吸取事故教训,提出防范措施等。
7、研讨交流:交流区队班组建设和基层人员培训工作经验,研讨强化现场安全管理、团队建设的主要措施等内容。
培训班将邀请有关专家、教授进行授课,采取案例教学、现场参观、研讨交流、视频展播等多种培训方式,培训班教学安排表详见(附件1),培训考核合格后,统一颁发中国煤炭工业协会监制的培训证书。
四、其他事项
1、本次培训由人教科统一组织实施,晋中市煤炭职工培训中心具体承办,各县(区、市)煤炭工业局接文后,迅速转发至各煤矿企业,并督促培训。
2、请各单位按照培训名额分配表(附件2)认真落实参培人员,务必于20xx年5月10日前将培训班报名表(附件3)电子版发送至邮箱。
3、参训人员报到时,需携带单位介绍信、本人身份证、学历证原件及复印件、近期免冠红底小二寸照片2张,以便建立培训档案。
机组长培训心得篇4
首先感谢各位凯邦领导给予我这次学习机会,更感谢各位员工对我工作的支持和帮助,我才能在凯邦改革发展的道路上,不落后于人,不仅在技术、管理上有所提高,更使自己从思想上进一步认识到作为一名班组长,首先要身先士卒以理服人,处处要起到带头作用,更要有奉献精神,要有分工,也要有合作,更要有检查,而且使自己做到心中有数,清楚每天该做些什么,怎么去做,不能盲目的毫无计划的去干,
作为班组长,应常常反思自己,在工作当中找答案,时时关心员工,和员工打成一片,为员工排忧解难,但不能搞帮派,要一视同仁,充分发挥员工的积极性和团队合作精神,充分利用各方面的信息是班组产生有效的生产和经济效益,最终做到按质、按量如期完成上级交给的各项任务。
在实际工作中,领导层的决策再好,没有员工的大力支持和密切配合,没有一大批基层员工把上级分配的任务当时来做,那就只能是一句空话,所以说基层的班组长是组织和领导者,又是执行任务的领头者。要想当好这个班组长,看班组长是否称职,是衡量你所带的员工对厂是否有贡献,在服务质量上是否有提高。作为班组长,要处处为总厂发展着想,时时提建议、想问题、想办法,听基层员工的心声,总结经验,发展好的方面,克服不足之处,才能促进总厂的发展,上一个新的台阶。
班组长是发展的带头者,又是实现目标的监督者,又是厂的上下桥梁者,又是实现目标的响应者,所以说作为一个班组长,技术骨干,要在业务上是一个多面手,只有这样,自己在工作上,才能做得更好,才能使领导放心。
班组是企业的细胞,企业的所有生产活动都在班组中进行,所以班组工作的好坏直接关系着企业发展的成败,只有班组充满了勃勃生机,企业才会有旺盛的活力,才能在激烈的市场竞争中长久地立于不败之地。班组长是上级与一线生产员工的主要沟通桥梁,起着承上启下的,上请下达的作用。同时,班组长也最接近基层,了解基层,能够及时发现基层员工存在或带有苗头性的问题。因此,班组长的管理好坏,对于全面提升总厂的管理水平,促进各项工作的健康、快速发展,具有重大的意义。那么,如何才能当好班组长呢?通过七天的学习和总厂各位领导的讲话,使我认识到,只有通过学习才能提高,在自己的工作岗位上怎么去做,订出计划,找准目标,大胆创新,大胆改革,才会有收获。作为总厂最基层的管理者——班组长,我谈谈个人的心得体会。我有以下几点感受:
一、时间上落实
我们班的时间都是相对固定的,如有改动我都会提前制定好新的时间或安排,因生产工作的特殊性,人员有交接班,同时时常有上级的学习文件或者会议精神需要传达,我们就必须在大部分员工下班后或上班前组织传达内容。每次上班时,若班组成员有迟到或早退的情况,我都会记录起来并让其本人签字,在全班通报以示提醒其它员工,并在处理违反这一规定的人和事时敢于较真,慢慢地坚持这一规定也就成了组员的自觉行动。
二、内容上切实
我们把“长”“短”配套,以“短”促“长”。“长”即以帮助组员树立正确的人生观、世界观,加强基础教育的学习,主要有理想、纪律、道德、法律、主人翁意识、班组精神等内容。“短”是指以解决组员日常工作、生活、学习中出现的各种思想问题为目的,针对组员出现的带倾向性、普通性的思想问题。在解决组员思想问题的同时,抓问题的实质,找出个别问题与普遍问题的联系,从这方面着手进行相对的全面教育。
三、方法上务实
大部分组员文化程序都不高,因此,要加强方法上的落实,主要也就是班长首先起到好的带头作用,有了好的标榜,自然能认真务实把事情做好。如果组员犯了错误,就拿最近的事来说,不带工作牌或迟到、早退等问题,我们可先给一个好的榜样,让他知道错在哪里,再让他自己反思,并让全班人知道,并做出处罚,可以得到提醒和警告的作用,并且能够让这位犯错误的同志深刻了解错误实质,从而增强职工的工作质量和效率的提高。
四、做好沟通
(1)与班员在思想上的交流。每个人的思想意识、家庭背景、文化素质、性格脾气都不一样,除了在档案资料上、在生活中进行观察了解、掌握班员的基本情况、摸清班员的心理想法外,在上班和休息时,可以与班员谈谈心、拉家常,询问班员在班里的感觉以及对班组骨干工作的评议和看法。以求达到思想上的统一,这样班员的心也就齐了,班员的凝聚力和向心力便大大增强了。
(2)工作上的表率和引导。对于厂里各项规章制度要带头遵守,严于律己、以身作则。特别是新来的班员 ,骨干就应该及时向他传授讲解,并且自己带头执行,不搞特殊化。班员看骨干,骨干怎么做,班员就跟着来。同时加强班员对岗上业务的培训,使其对自己的工作职责了解透彻,爱岗敬业,对他们在岗位上犯的错误,应该把错误的性质及危害性,会产生什么后果,细致地分析给班员听,切不可动不动就发脾气,大动肝火。人都是有自尊和体面的,这样效果还会适得其反,班员也难以接受和理解。
(3)生活上的体贴关心。班员到工作点上一时很难适应环境,情绪也不稳定。应尽可能地为他们着想,解决后勤保障,创造生活空间,每个人出门在外,不免有些孤单寂寞和思乡之情。其实,有时候自己一句关心的话语,一句诚挚的问候,都会使人倍感温暖和亲切。逢节假日,组织多搞一些健康有益的娱乐活动,充分让班员发挥自己的专长。使他们从心底感受到大集体、大家庭的温暖和谐气氛。使班员在玩的时候放松,心情保持舒畅。这样上班工作时就没有任何思想包袱,尽职尽责做好自己的工作。
总之,通过创新“优质服务”策略,提高认识,明确职责,创新服务格局,扩大服务层面,标本兼治,综合治理,建立完善的服务体系,提高服务水平,将优质产品连续不断地提供给客户。通过“优质服务”,深化“创一流”活动,让客户满意,让总厂放心,使凯邦电机厂在激烈的市场中立于不败之地。
通过这次学习,使自己认识到一个班组长,首先要定出目标,掌握技术,员工才有一个奋斗前进的方向;我要更加努力提高自己的管理水平和组织能力,使自己在以后的工作中,有所提高,在技术、计划、任务安排上,善用人才、合理分工。为凯邦今后发展,做出应有的贡献。
机组长培训心得篇5
20xx年3月12日—4月1日,x股份华东事业部第一期至第三期班组长培训,在集团公司领导的重视,人力资源部的周密安排及各公司通力协助下,在全体学员的密切配合、共同努力下,历时21天时间,按计划顺利完成了全部任务。
按照本次班组长培训的计划,事业部所有分子公司180余名班组长共分三批,在无锡市国防教育基地进行全封闭式的培训,为期21天的历程。
参加本次培训的班组长学员共计180余人。其中第一批62人,第二批54人,第三批64人。都是来自华东事业部七家分子公司及销售公司,大部分为企业的中坚力量,他们都是企业岗位中不可或缺的人员。40岁以上人员占比例的30%,年龄最大56岁,最小20岁,平均年龄在37岁,学历程度从初中到本科,其中中专以上人员是比例的40%。本次培训采取的方式是以半天军事化培训和半天专业知识学习。每天在室内与室外安排大量的团队活动,本次培训人员是来自各个分子公司的.不同班组长,在为期的几天内大家从互相认识到互相帮助,展现了企业该具有的和谐精神,其中内容设计有:溧阳天山魏晓燕的企业文化传承;毛建军的安全和现场管理;王建强的班组成本核算。宜兴天山许小玲的班组管理方法。集团公司技术备件中心刘天夫的机械知识;郑拥军的电器基础知识;集团公司渠华的水泥生产工艺流程;溧水天山魏国玺的组织管理及集团公司人力资源部王淑琴的人力资源等方面入手,为一线工人讲演在企业里怎样做好“引导者”的管理理念。在为期21天的培训中,无锡市国防教育基地的徐教官以严肃庄重的心里坚持严格要求,严格训练,学员们发扬不怕苦、不怕累、坚持到底的精神,在教官、内训师的认真、悉心指导下,学到了基本的军事理论知识和一定的军事技能,展现军事风采,弘扬企业精神。初步掌握了各类专业知识,以坚守责任,创新思想,汇聚能量为基础加强了组织纪律性,树立了集体主义思想,提高了学员凝聚力和战斗力。学员懂得如何培养自身的素质,使得自己以身作则做好兵头将尾的工作,全面发展让学员知识不但有了量的提升,且有了质的飞跃。
机组长培训心得篇6
班组是企业组织生产经营活动的基本单位,是企业最基层的生产管理组织。企业的所有生产活动都在班组中进行,所以班组工作的好坏直接关系着企业经营的成败,只有班组充满了勃勃生机,企业才会有旺盛的活力。
一个班组是一条工作链或一条服务链。一个企业的基层管理者如果像一个混凝土柱子,班组长就是牵连沙子和石子之间的钢筋架。只有钢筋有序的排列在钢架内,紧密的连接着石子和沙子,真正起到自己的作用,构建起来的柱子才会更坚固,才能经得起暴风雨的洗礼。
班组长作为一个企业的基层管理要做到上对上司负责,下对员工负责,班组长既是承上启下的桥梁,又是员工联系领导的纽带,时常的工作中担任着管理和被管理的角色。班组中的领导者就是班组长,班组长是班组生产管理的直接指挥和组织者,也是企业中最基层的负责人,属于兵头将尾,是一支数量非常庞大的队伍,也是质量、成本、产量指标达成的最直接的责任者,是班组的主心骨和带头人。
作为一名班组日常勤务的直接指挥和组织者,不应该仅仅停留在通常的人员调配和生产排班上,应该业务技术术培训以及安全操作,任务执行力度,团队管理和建设等充分发挥出班组长的领导和示范作用。在工作中班组长应保持健康的心态和宽阔的胸怀,正确对待下属和上级,要善于发现问题,敢于直面问题,勇于解决问题,才能在化解矛盾和解决问题中实现新的突破,在解决难题中求深造,在克服困难中前进,并不断地进行知识更新。
作为班组长要有较强团队意识和组织能力,有较清晰的管理思路,协调能力和沟通能力强。在工作中要做到多请示,多汇报;多学习,多实踮;多发现,多整改;多沟通,多讨论;多创新,多论证。对员工在工作、生活上多加关心和了解,让员工自然的感受到你的热情,感觉到集体的温馨,从而加强员工的责任感,荣誉感和团队意识。建设团队精神,培养队伍的凝聚力,发扬我们优良的传统能吃苦,肯奉献,干打硬仗;聚人心,勇进取,争创一流。
在工作中对生产质量和生产安全要严格监督,严格要求,发现问提要及时提出提出问题,汇报问题,解决问题。始终坚持安全第一,预防为主,综合治理,持续发展的发展思路。增强安全生产防范意识,严格按照生产流程和职责进行安全生产,做好现场执勤岗位安全生产责任人的工作。勇于去承担工作中的责任,不拖拉,不隐瞒,不误报,虚心接受领导的教导和批评。勤务工作中要奖罚分明,不讲哥们主义,不讲个人主义,事实求是,立场坚决,目标明确。
在工作计划中要从实际出发,计划要有可行性,不盲目决定和执行,多征求队员的意见。对于生产中出现的问题,要仔细认真分析清事物的本质,查找生产环节中的薄弱点,提出合理化建议,制定符合生产运营的计划,带头和监督进行实施。
在生产业务技能方面,要熟练掌握各种设备设施的性能,技术操作要求和维护技术要求。作名业务技能能手,可以拿得出,用的上。在新人员业务技能培训中,要严格要求,严格执行,把自己掌握的知识技能传授于他人,要充分发挥以老带新的优良作风。
经过培训使我受益匪浅,懂得了,什么事班组长?班组长在基层管理中的作用是什么?怎么样才能做好一名班组长?班组长在管理中所承担的责任的重要性。在以后的工作中我会努力工作,认真学习,用实际行动说话。
机组长培训心得篇7
这次在人力资源部的安排下经过两天的班组长安全培训,使我对班组概念、班组长的使命、任务、班组管理、以及公司安全管理等方面的认识都有了较大的提升。班组是公司的最小单位,班组管理是公司管理的基础,加强班组建设是公司组织变革的需要,是提高公司执行力的需要,是提升经济效益的需要,是保障安全生产的需要,是建设和谐企业的需要,是员工全面发展的需要。我作为物资供应部业务组组长,工作范围主要是整个公司生产所需原材料和辅助材料的管理。以前,工作重心只放在材料采购和签订合同等方面,对安全管理方面下的功夫不大。通过本次培训,今后我要进一步加强班组管理工作,特别是要加强安全管理工作。
班组是执行各项规章制度和安全规程的主体,也是违章作业和人员伤亡事故的前沿阵地。因此能否将安全管理的有效性深入到班组的安全建设,是大幅度降低安全事故,实现安全生产的关键。只有搞好班组的安全管理,班组的生产才能安全,公司的安全生产才有保障,公司才能取得更大更好的经济效益。加强班组安全管理应当到以下几点:
1、认真开好班前、班后会,全面贯彻安全生产方针、政策,落实好具体安全工作。
2、进行安全教育、纪律教育,制止违章,努力形成本班组的安全文化“没有消除不了的隐患,没有避免不了的事故”。
3、加强班组安全学习,树立安全意识,是班组成员由“要我安全”转变为“我要安全、我会安全、我能安全。”
4、安全管理必须做到分工明确,责任到人,建立健全的体系和责任制,要强化岗位工作效率,更强调全班整体有效的配合。
5、班组安全管理工作应该从“事后把关”。即侧重于事故发生的分析,从而吸取教训防止再犯;转移到立足于“事先预防”,即对已定计划继续拧预先分析,找出潜在的各种隐患。
总之,安全管理工作只有起点没有终点,企业的生存发展成在班组、败亦在班组。我们要提高对班组建设的重视,把加强班组建设放在一个新的高度,高起点、高标准、严要求,切实做好班组管理工作。
物资供应部
20xx年5月18日
机组长培训心得篇8
这次厂组织了班组长的学习培训,主要目的是提高每个班组长的能力和素质培养,从而更好的完成工作,提高工作效益。这次学习扔使我受益匪浅,更使我了解做一名班组长的使命和职责。
班组长是兵头将尾,是指挥者也是监督者,起着一线的指挥工作,确保工作的质量和直接的结果。班组长要充分发挥全班的积极性,保证安全第一,提高生产的质量和效益,降低成本,防止工伤和重大的伤亡,这是一名班组长最起码应该做到的工作。做一名合格的班组长应该就要提高自己的能力,注意自我反思,要辅助上级,完成生产管理职责。因此班组长影响决策的实施,也起到承上启下的作用,更是一名领导者和直接的生产者。
首先,作为一名班组长,我自信自己已经能与我的班组职工相处得很融洽,也能得到班组职工支持和帮助,班组的各方面工作都能顺利的开展,但是这些工作是否真正能得到领导的认可,你本人是否能得到领导的欢迎却是个值得认真思考的问题?下面我谈谈我的感想。
第一、让上司作选择题,自己作思考题。
这一点我认为是最重要的,也是领导最喜欢的方式。对于一个领导来说,他每天要面对许多的问题,他根本没有太多的精力来逐一思考处理来自基层班组的全部问题。这时候作为一名杰出的班组长,我们就要把班组中遇到的问题先自己仔细思考并提出一系列行之有效的解决方案,然后在向领导汇报,让领导来决定哪个方案的合理性和可行性最强。这样,你本人的能力也在思考解决问题的过程中得到了不断提高,领导也能在“做选择题”的过程中不断认可你的能力,从而使你成为一个受到领导欢迎和赏识的下属。
第二、比别人多做一步。
举一个例子:领导叫两个人去菜场问白菜的价格,其中一个去了很快就回来了,他带回了白菜的价格;而另外一个过了很久才回来,他不仅仅带回了白菜的价格,也带回了菜场上所有其他蔬果禽蛋的价格,并且为领导制定了一个行之有效的采购计划。我想大家都能猜到谁将会得到领导的重用了吧。对,就是后者。他为什么能得到领导重用?就是因为他能比别人多做一步。今天你比别人多付出一点,明天你就能得到比别人更多的回报。要做到比别人多做一步,重要的是自己要有积极主动的心态,要有比别人更加深入的思考,要有比别人更加迅速的行动,要比别人付出更多的努力。我相信一句话:天道酬勤
其次,我体会到责任心的种要性。
因此,作为班长,我认为不断培养和加强班组职工的责任心是我最基础最重要的工作之一。
第一,培训。
作为班组长,要充分认识培训的重要性,认真做好班组的基础培训工作,要清楚的告诉班组职工,责任心的表现是什么,他要怎么做才是对的,应该按照什么方法去做等等,这就是我们日常的技术培训和安全培训中都在做得事情。
第二,规程。
规程就是我们工作中的各种技术和安全规程,我们要通过“培训”让班组职工充分学习掌握它们,并在工作中督促班组职工按照正确的规程和方法去开展工作。这些正确的规程和方法将在工作中逐步的潜移默化成为班组职工的责任心、能力和习惯。因此,在工作中对规程的正确执行非常重要,是班长必须花大力气去督促的。
第三,制度。
制度的重要性不言而喻。作为一线生产班组,制度更是保证班组安全运作的基矗制度是一种强制力,他能很明确的告诉班组职工如果做错了事会受到什么样惩罚,班组职工就能按照制度的要求去做。在这种强制力的压力下,职工的责任心会自然地增强,因为责任心不强就会出错,出错就会受到制度的惩罚和约束,这就要求班组职工以很强的责任心去开展工作。
第四,氛围。
氛围就是班组的学习氛围,安全氛围,责任心氛围。近墨者黑,近朱者赤。任何一名职工,在一个良好的氛围中都会不知不觉地被影响,从而做出与这个氛围相符的事情。因此,我觉得班组长要致力于建立良好的班组氛围,以带动全体班员的共同进步。
总之,这四种方法的综合运用,目的是使班组职工以极强的责任心开展工作的意识和行动成为一种良好的工作习惯,当好的习惯在好的氛围中得到不断的加强后,就能成为班组职工的一种素质。这种强责任心的素质是我们基层班组、是一个企业最宝贵的财富.班组长是生产的组织领导者和指挥者,也是直接生产者,他综合素质的高低,将影响班组管理的成败。所以,班组长不仅要具备善于沟通、执行力要强、具有影响力、关注细节、带领团队等管理能力,还要掌握足够的技术技能、与人共事的人事技能和思想技能。同时,班组长要明确自己在班组中的角色,对自己的定位要清楚,明白工作的主要职责,了解上级领导对自己的期望和班组员工对自己的期望。要能带领班组成员,设定一个共同明确的目标,朝着这个目标制定行动方向,有计划、有步骤的实施。